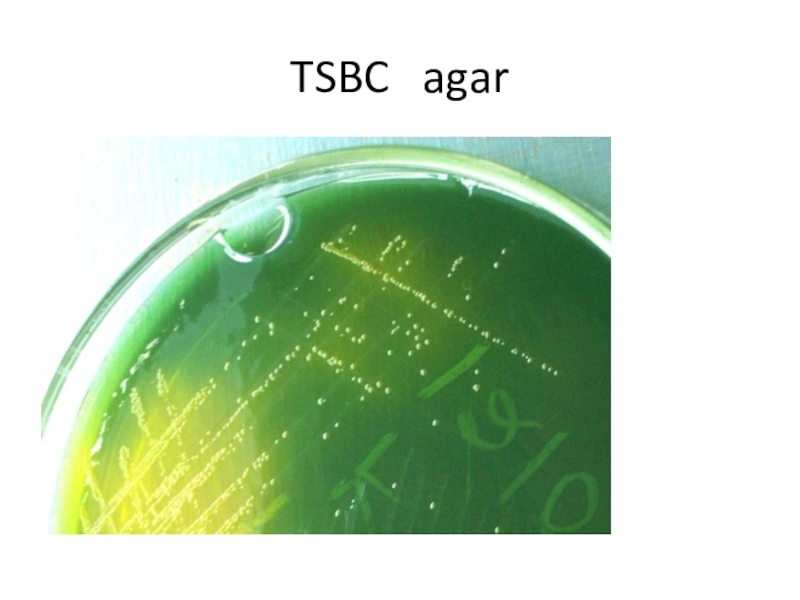

Слайд 1CHOLERA
Department of Microbiology, Virology & Immunology
Ass. Prof. E. O. Kravtsova
Слайд 2Cholera dates back to the most ancient times. There were
7 pandemics
1. 1817-1823
2. 1826-1837
3. 1846-1862
4. 1864-1875
5. 1883-1896
6. 1900-1926 Caused
by V.cholera
7. 1961-1963 Caused by V.cholera El Tor
Слайд 31892 cholera outbreak in Hamburg, Germany, hospital ward
1892 cholera outbreak
in Hamburg, disinfection team
Слайд 4The bacterium had been originally isolated in 1854 by Italian
anatomist Filippo Pacini, but his results were not widely known
around the world.
Filippo Pacini
Слайд 5John Snow
John Snow (1813-1858) found a link between cholera and
contaminated drinking water in 1854.
He proposed a microbial origin
for epidemic cholera in 1849 and in his major state of the art review of 1855 he proposed a substantially complete and correct model for the aetiology of the disease.
In two pioneering epidemiological field-studies he was able to demonstrate that human sewage contamination was the most probable disease vector in two major epidemics in London in 1854.
Слайд 6Robert Koch identified
V. cholerae in 1885.
Robert Koch
Слайд 7Robert Koch
Isolator of V.cholera
Nobel of Medicine,1905
Слайд 9Taxonomy
FAMILY VIBRIONACEAE
Genus: Vibrio
Species: V.cholerae
Biovars: Cholerae (1883) and El Tor (1906)
Слайд 10 Although there are more than 130 different serogroups of
V. cholerae, most epidemics are associated with a single serotype,
V. cholerae O1.
In 1992 V.cholerae serogroup O139 (Bengal) was registered as a new causative agent of cholera.
Слайд 13FAMILY VIBRIONACEAE
VIBRIO CHOLERAE
Gram «-» curved rods
Spores «-»
Capsula «-»
They are motile - monotrichous
V. cholerae has two circular chromosomes
Aerobes or
facultative anaerobes
Growth best in alkaline nutrient agar, pH 8.2
at t= 37C
Colonies are small, moist, translucent, round, bluish.
In 1% peptone water, growth occurs in about 6 hours as surface pellicle.
Слайд 15Biochemical properties
Ferment glucose, mannitol, maltose, mannose, sucrose (acid), but not
arabinose and lactose.
Indole is formed H2S «-»
Nitrates
are reduced to nitrites
Catalase and oxidase test are positive
Methyl red and urease test are negative
Gelatin is liquefied
Слайд 16Heiberg, group 1
Mannose «+» acid
Saccharose «+» acid
Arabinose «-»
Слайд 17VIBRIO CHOLERAE
Antigens: H - flagellar , is common for
genus Vibrio
O-somatic, is type specific
O1 and O139
O1 - A, B, C.
AB – Ogava, AC – Inaba, ABC – Hikojima.
Слайд 18Resistance
Susceptible to heat, drying, acid and common disinfectants but resist
alkaline medium.
Destroyed at 55С in 15 minutes
Killed in few minutes
in gastric juice.
Survive more 4 weeks in river water.
On food stuff survive for 10 days.
Слайд 19Toxin Production
V.cholera produced enterotoxin called cholerogen which has a powerful
toxic effect and causes profuse, watery diarrhea.
V.cholera produced collagenase,
decarboxylase, lipase, mucinase and neuraminidase
Слайд 20Cholerogen
Toxin binds to the plasma membrane of intestinal epithelial cells
and releases an enzymatically active subunit that causes a rise
in cyclic adenosine monophosphate (cAMP) production.
The resulting high intracellular cAMP level causes massive secretion of electrolytes and water into the intestinal lumen.
Слайд 21Cholera enterotoxin (cholerogen-exotoxin) is produced by the pathogen as it
grows in the infected human gastrointestinal tract.
The enterotoxin, which
consists of two molecular subunits, attaches to the cell membranes of intestinal epithelial cells.
The B subunit binds to molecules on the cell surface and propels the smaller A subunit into the cell, where it stimulates adenylate cyclase, a membrane-associated enzyme that catalyzes the formation of cyclic AMP (cAMP).
The accumulation of cAMP results in massive secretion of salts and water from each affected cell.
The rapid loss of water produces a watery diarrhea that may cause a cholera patient to lose 20 liters of fluid daily.
Such a dramatic loss of water leads to severe dehydration, thickening of the blood, a decrease in blood volume, circulatory collapse (shock), and death if not rapidly treated.
Слайд 22Disease in Men
Cholera is transmitted by the fecal-oral route
Source
of infection: patients, carriers and contaminated water
Symptom of diseases:
Weakness
Vomiting
Diarrhea
Слайд 23
Scanning electron microscopy during early infection.
Curved vibrios adhering to epithelial surface.
Vibrio cholerae attachment and
colonization in experimental rabbits. The events are assumed to be similar in human
Слайд 25Symptom of disease
rice water stool
Слайд 27Rapid Diagnosis
Material: feces, vomit, drinking water
Inoculate into 3 test tubes
Put in thermostat (t=37C, 6 hours)
Results:
1% peptone water
1% peptone water 1% peptone water
+ 01 antisera + 0.5% starch
Prepare micropreparation
Gram’s method
Motility exam
Slide Agglutination
with antisera
If <+> & present cholera
clumps
Add Lugol iodine 2-3 drops
Starch + Lugol => blue
V.cholera ferment starch => color not change
Слайд 29DifferIdeIens of Biovars of Cholera Vi
Слайд 30Treatment and Immunoprophylaxis
In treating cholera, antibiotics, and continual replacement
of fluids and electrolytes are recommended. The fluid and electrolyte
balance can be maintained by the oral or intravenous administration of electrolytes in the presence of glucose. The glucose is essential because it stimulates uptake of sodium chloride and subsequent osmotic absorption of water.
Two types of vaccines against cholera are available, but they are only about 50 percent effective and confer immunity for only 6 months. In its current state, the vaccine is useless for preventing disease among residents of endemic areas. Several newer vaccines, some composed of toxic fragments, are being tested for use in endemic areas.
Слайд 31Treatment
Cholera bacteriophages
Antibiotic of Tetracycline group
Pathogenic therapy
Control of dehydration
Слайд 32Prophylaxis
Immunization with vaccine
Water supply disinfection
Hospitalization
Isolation